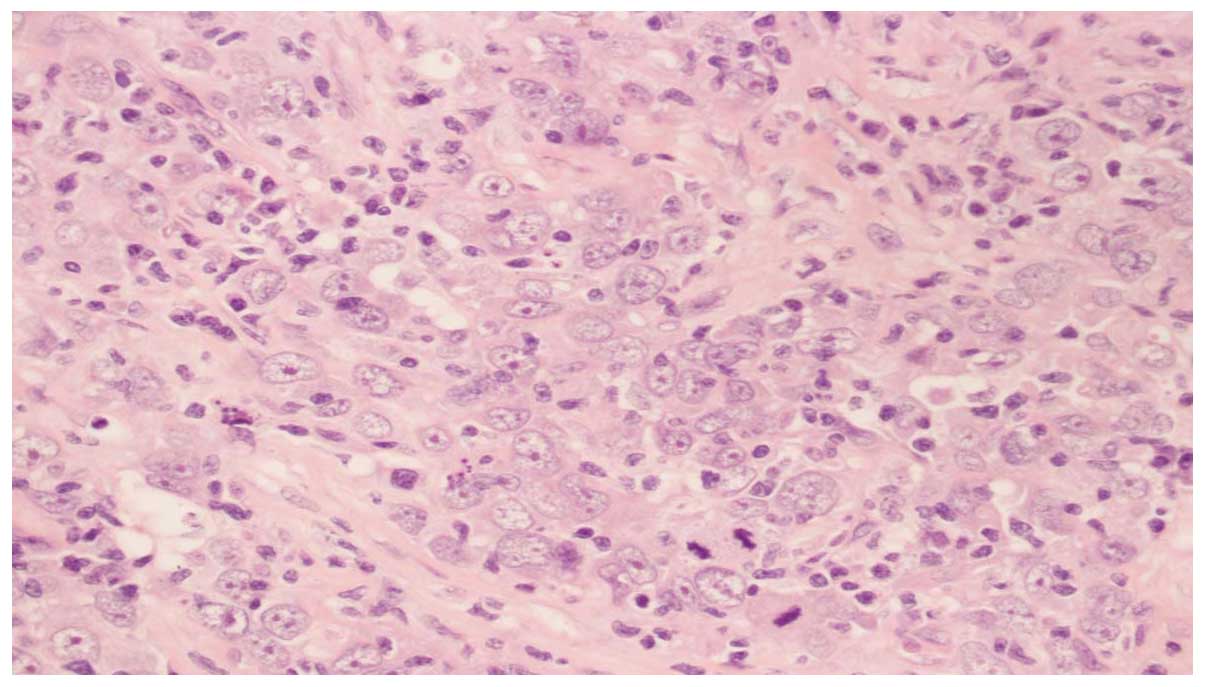

Introduction
Neuroendocrine carcinomas consists of a
heterogeneous group of neoplasms, which arise from peptide- or
amine-producing endocrine cells throughout the body (1). The most frequent primary locations of
the tumors are pulmonary. The extrapulmonary counterpart is rarely
encountered, and has been identified in the gastrointestinal tract,
pancreas, genitourinary tract, lymphatics, thymus and peritoneum
(2). In the genitourinary tract,
the bladder is the most common primary site of the disease, while
tumors originating from the ureter are extremely rare (3). Due to its rarity, little is known
concerning the natural history of ureteral small cell
neuroendocrine carcinoma. The current report presents a case and
systematic literature review on the clinical presentation and
treatment of this rare tumor.
Case report
A 65-year-old female presented with right-sided back
pain that had been present for one month. The patient had no
significant past medical or family history of disease. The physical
examination was normal, and laboratory test results showed normal
liver function, electrolytes, carcinoembryonic antigen and
carbohydrate antigen 19-9. The patient provided written informed
consent. A computed tomography (CT) scan of the abdomen revealed a
mass measuring ~5×4 cm in the right ureter, with light
hydronephrosis (Fig. 1). A chest CT
was also reviewed and no primary or metastatic lung lesions were
revealed. The patient underwent a right nephroureterectomy and a
mass was found within the wall of the right ureter, with grossly
negative surgical margins. The microscopic examination showed that
the tumor was composed of small cells (Fig. 2). The immunohistochemical staining
for the tumor cells was positive for cluster of differentiation
(CD)56 (Fig. 3A), chromogranin A
(CgA; Fig. 3B) and synaptophysin
(Syn; Fig. 3C). Moreover, the tumor
expressed high mitotic activity of >20 mitoses per 2
mm2, and the Ki-67/MiBi index was 67% (Fig. 3D). The patient was diagnosed with
small cell neuroendocrine carcinoma of the ureter. The
post-operative recovery of the patient was uncomplicated, but the
patient returned 4 months later, with CT scans revealing
recurrences in the retroperitoneum (Fig. 4A). Chemotherapy was administered and
following 80 mg/m2 intravenous irinotecan on days 1 and
8 and 25 mg/m2 cisplatin on days 1–3, every 21 days for
4 cycles, CT scans showed a considerably smaller tumor (Fig. 4B). During the regular follow-up
examinations, the tumor remained stable (Fig. 4C).
Discussion
Neuroendocrine carcinomas arising from the urinary
tract are extremely rare and represent <0.5% of urinary tract
tumors. The bladder is the most common location of small cell
neuroendocrine carcinomas, whereas they are extremely rare in the
ureter (3), with only 24 previous
cases found in the literature since the first case in 1986, which
was reported by Ordonez et al (4). To the best of our knowledge, the
present case is the twenty-fifth to be reported and the first case
to be reported in the Chinese population.
Due to its rarity, the origin of these tumors
remains controversial and warrants further studies. The following
four hypotheses have been suggested for the origin of the tumors:
i) From the urothelium with neuroendocrine differentiation; ii)
from neuroendocrine cells present in the urinary tract; iii) from
the entrapped neural crest in the ureter during embryogenesis; and
iv) from undifferentiated stem cells that differentiate towards a
urothelial or squamous cell lineage (5,6).
These tumors are commonly observed in the sixth
decade of life, with a slight female preponderance, as presented in
the current case report. Hematuria and pain are the most commonly
reported symptoms of the tumor, with only a few patients exhibiting
paraneoplastic syndrome by inappropriate antidiuretic hormone
secretion, ectopic adrenocorticotropic hormone production and
hypophosphatemia. The current patient presented with flank pain
only, with no hematuria or endocrine syndrome.
The diagnosis of these tumors depends on their
pathology and immunohistochemistry. Histologically, these tumors
are rarely pure and are frequently admixed with other components,
including transitional cell and squamous cell carcinomas,
adenocarcinoma, chondrosarcoma and leiomyosarcoma (7). On light microscopy, these tumors
consist of small cells, with prominent nuclei, scant cytoplasm and
granular chromatin. In addition, a high mitotic index may be
observed. Furthermore, immunohistochemical staining for specific
neuroendocrine markers, including CD56, neuron-specific enolase,
Syn and CgA, may distinguish neuroendocrine small cell carcinoma
from other tumors and be useful for determining the correct
diagnosis (8). During the
diagnosis, it is important to exclude lung small cell carcinoma
metastasis to the ureter, although it is rarely encountered
(9).
The staging of urinary tract small cell carcinoma is
similar to that of lung small cell carcinoma, which includes the
following two stages: i) Limited disease, the tumor may be
encompassed within a tolerable radiation therapy port, whether or
not the tumor is confined to the primary site, and with or without
regional lymph node involvement; and ii) extensive disease, the
tumor is spread beyond the locoregional boundaries and exceeds a
tolerable radiation therapy port (10).
The clinical courses of these tumors are usually
aggressive and median survival is only 8.2 months. There exists a
high incidence of early dissemination and a frequent recurrence of
these tumors, which may be due to the occult metastasis at initial
presentation. Majhail et al previously reported that the
incidence of relapse is ≤60% (11).
In the present case report, the patient returned with recurrences
in the retroperitoneum 4 months after surgery.
The optimal treatment of small cell neuroendocrine
carcinoma of the ureter has not been well established. A number of
clinicians suggest multimodality therapy, including surgery,
radiation therapy and adjuvant chemotherapy, which may confer
improved survival rates (12).
Previously, Ouzzane et al (4) reported that the median survival time
of patients with upper urinary tract small cell carcinoma was 24
months for those administered with chemotherapy versus 12 months
for those who underwent surgery alone, however, no statistically
significant differences were identified (P=0.56). Furthermore,
patients administered platinum-based chemotherapy appeared to
exhibit a higher median survival time than those who were not
administered a regimen containing platinum (24 vs. 8 months,
respectively; P=0.12). The tumor site, i.e., whether the tumor is
in the renal pelvis or ureter, has not been significantly
associated with survival (4). In
the previously reported 24 cases of ureteral small cell
neuroendocrine carcinoma, 8 cases received chemotherapy, and among
those, only 3 cases were administered a platinum-based chemotherapy
with a platinum and etoposide regimen. In the present case, due to
the fatigue of the patient and avoiding the hematological toxicity
of etoposide, the patient received 80 mg/m2 irinotecan
on days 1 and 8 and 25 mg/m2 cisplatin on days 1–3,
every 21 days for 4 cycles. No serious toxicity was observed and
the patient endured treatment. Following the treatment, CT scans
showed a considerably smaller tumor (Fig. 3B), and during the regular follow-up
examinations, the tumor remained stable. The clinical results
indicated that irinotecan and platinum may also be effective for
ureteral neuroendocrine small cell carcinoma. To the best of our
knowledge, there is only one previous study concerning this
combination of therapy for these tumors (13). It is possible that the combination
of irinotecan and platinum may be an alternative therapy for ureter
neuroendocrine small cell carcinoma in the future, such as that in
small cell lung cancer.
However, for the majority of patients with small
cell neuroendocrine carcinoma of the ureter, these treatments are
not enough to achieve cure and other strategies are required to
improve therapy for this lethal cancer. New molecular therapeutic
approaches have been previously investigated for these tumors. It
has been reported that these tumors involve c-kit expression and
platelet-derived growth factor receptor-α (PDGFRA) mutation
(14), which may be potential
therapy targets.
In conclusion, small cell neuroendocrine carcinomas
of the ureter are rare tumors and few cases have been previously
reported. Surgery combined with adjuvant chemotherapy may confer
improved survival rates. New therapeutic approaches for these
tumors, including agents targeting c-kit and PDGFRA, are also
currently under investigation.
Acknowledgements
The present study was sponsored by grants from the
Zhejiang Provincial Science and Technology Project (no. 2011C23087)
and the Zhejiang Provincial Traditional Chinese Medicine Science
Research Foundation (no. 2012ZA078).
References
|
1
|
Volante M, Rindi G and Papotti M: The grey
zone between pure (neuro) endocrine and non-(neuro) endocrine: a
comment on concepts and classification of mixed exocrine-endocrine
neoplasms. Virchows Arch. 449:499–506. 2006. View Article : Google Scholar : PubMed/NCBI
|
|
2
|
Mackey JR, Au HJ, Hugh J and Venner P:
Genitourinary small cell carcinoma: determination of clinical and
therapeutic factors associated with survival. J Urol.
159:1624–1629. 1998. View Article : Google Scholar : PubMed/NCBI
|
|
3
|
Chang CY, Reddy K, Chorneyko K and Kapoor
A: Primary small cell carcinoma of the ureter. Can J Urol.
12:2603–2606. 2005.PubMed/NCBI
|
|
4
|
Ouzzane A, Ghoneim TP, Udo K,
Verhasselt-Crinquette M, Puech P, Betrouni N, Rouprêt M, Villers A,
Leroy X and Colin P: Small cell carcinoma of the upper urinary
tract (UUT-SCC): Report of a rare entity and systematic review of
the literature. Cancer Treat Rev. 37:366–372. 2011. View Article : Google Scholar : PubMed/NCBI
|
|
5
|
Banerji JS, Korula A and Panicker JB:
Multicentric small cell neuroendocrine neoplasm of the renal pelvis
and ureter with concomitant focal high-grade urothelial carcinoma
of the ureter: A case report. Indian J Uro. 24:571–574. 2008.
View Article : Google Scholar
|
|
6
|
Fettissof F, Dubois MP, Lanson Y and
Jobard P: Endocrine cells in renal pelvis and ureter: an
immunohistochemical analysis. J Urol. 135:420–421. 1986.PubMed/NCBI
|
|
7
|
Kim TS, Seong DH and Ro JY: Small cell
carcinoma of the ureter with squamous cell and transitional cell
carcinomatous components associated with ureteral stone. J Korean
Med Sci. 16:796–800. 2001. View Article : Google Scholar : PubMed/NCBI
|
|
8
|
Busby JE, Brown GA and Tamboli P: Upper
urinary tract tumors with nontransitional histology: A
single-center experience. Urology. 67:518–523. 2006. View Article : Google Scholar : PubMed/NCBI
|
|
9
|
Brennan SM, Gregory DL and Stillie A:
Should extrapulmonary small cell cancer be managed like small cell
lung cancer? Cancer. 116:888–895. 2010. View Article : Google Scholar
|
|
10
|
Kim JH, Lee SH, Park J, Kim HY, Lee SI,
Nam EM and Park JO: Extrapulmonary small-cell carcinoma: a
single-institution experience. Jpn J Clin Oncol. 34:250–254. 2004.
View Article : Google Scholar : PubMed/NCBI
|
|
11
|
Majhail N, Elson P and Bokowski RM:
Therapy and outcome of small cell carcinoma of the kidney: reports
of two cases and a systematic review of the literature. Cancer.
97:1436–1441. 2003. View Article : Google Scholar : PubMed/NCBI
|
|
12
|
Essenfield H, Manivel JC, Benedetto P and
Albores-Saavedra J: Small cell carcinoma of the renal pelvis: a
clinicopathological, morphological and immunohistochemical study of
2 cases. J Urol. 144:344–347. 1990.PubMed/NCBI
|
|
13
|
Masui K, Kamba T, Watanabe J, et al: A
case of small cell carcinoma of the ureter. Hinyokika Kiyo.
54:411–413. 2008.(In Japanese).
|
|
14
|
Terada T: Primary small cell carcinoma of
the ureter: a case report involving immunohistochemical and
molecular genetic analyses of KIT and PDGFRA genes. Pathology.
42:101–102. 2009. View Article : Google Scholar : PubMed/NCBI
|